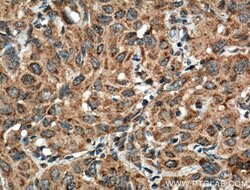
ATF6 Mouse anti-Human, Mouse, Rat, Clone: 3B7E4, Proteintech:Antibodies:Primary

Learn More
ATF6 Mouse anti-Human, Mouse, Rat, Clone: 3B7E4, Proteintech
Mouse Monoclonal Antibody
145.00€ - 410.00€
Specifications
| Antigen | ATF6 |
|---|---|
| Clone | 3B7E4 |
| Concentration | 1 mg/mL |
| Applications | Immunofluorescence, Immunohistochemistry (Paraffin), Western Blot, Immunocytochemistry |
| Classification | Monoclonal |
| Product Code | Brand | Quantity | Price | Quantity & Availability | |||||
|---|---|---|---|---|---|---|---|---|---|
| Product Code | Brand | Quantity | Price | Quantity & Availability | |||||
|
16848555
|
Proteintech
66563-1-IG-20UL |
20 μL |
145.00€
20µL |
Please sign in to purchase this item. Need a web account? Register with us today! | |||||
|
16838555
|
Proteintech
66563-1-IG-150UL |
150 μL |
410.00€
150µL |
Please sign in to purchase this item. Need a web account? Register with us today! | |||||
Description
The fully glycosylated form of ATF6, a 670 amino acid protein, exhibits an electrophoretic mobility of ∽90 kDa in denaturing SDS-gels, in part because of the glycosylated modifications. ATF6 has 3 consensus sites for N-linked glycosylation and exists
ATF6 is a transcription factor that acts during endoplasmic reticulum stress by activating unfolded protein response target genes. It binds DNA on the 5′-CCAC[GA]-3′half of the ER stress response element (ERSE) (5′-CCAAT-N(9)-CCAC[GA]-3′) and of ERSE II (5′-ATTGG-N-CCACG-3′). Binding to ERSE requires binding of NF-Y to ERSE. ATF6 could also be involved in activation of transcription by the serum response factor. ATF6 exists as a homodimer and heterodimer with ATF6 beta. The dimer interacts with the nuclear transcription factor Y (NF-Y) trimer through direct binding to NF-Y subunit C (NF-YC). It Interacts also with the transcription factors GTF2I, YY1 and SRF. Under ER stress the cleaved N-terminal cytoplasmic domain translocates into the nucleus. The basic domain of ATF6 functions as a nuclear localization signal and the basic leucine-zipper domain is sufficient for association with the NF-Y trimer and binding to ERSE. During the unfolded protein response an approximately 50 kDa fragment containing the cytoplasmic transcription factor domain is released by proteolysis. The cleavage seems to be performed sequentially by site-1 and site-2 proteases. ATF6 is N-glycosylated, phosphorylated in vitro by MAPK14/P38MAPK and belongs to the bZIP family.Specifications
| ATF6 | |
| 1 mg/mL | |
| Monoclonal | |
| Liquid | |
| RUO | |
| PBS with 50% glycerol and 0.1% sodium azide; pH 7.3 | |
| ATF6, ATF6 alpha, ATF6A | |
| Atf6 | |
| IgG1 | |
| Protein G | |
| Antibody |
| 3B7E4 | |
| Immunofluorescence, Immunohistochemistry (Paraffin), Western Blot, Immunocytochemistry | |
| Unconjugated | |
| Mouse | |
| Mouse, Human, Rat | |
| F6VAN0, G3V909, P18850 | |
| 226641, 22926, 304962 | |
| ATF6 Fusion Protein Ag21456 | |
| Primary | |
| -20°C | |
| ATF6 |
Your input is important to us. Please complete this form to provide feedback related to the content on this product.